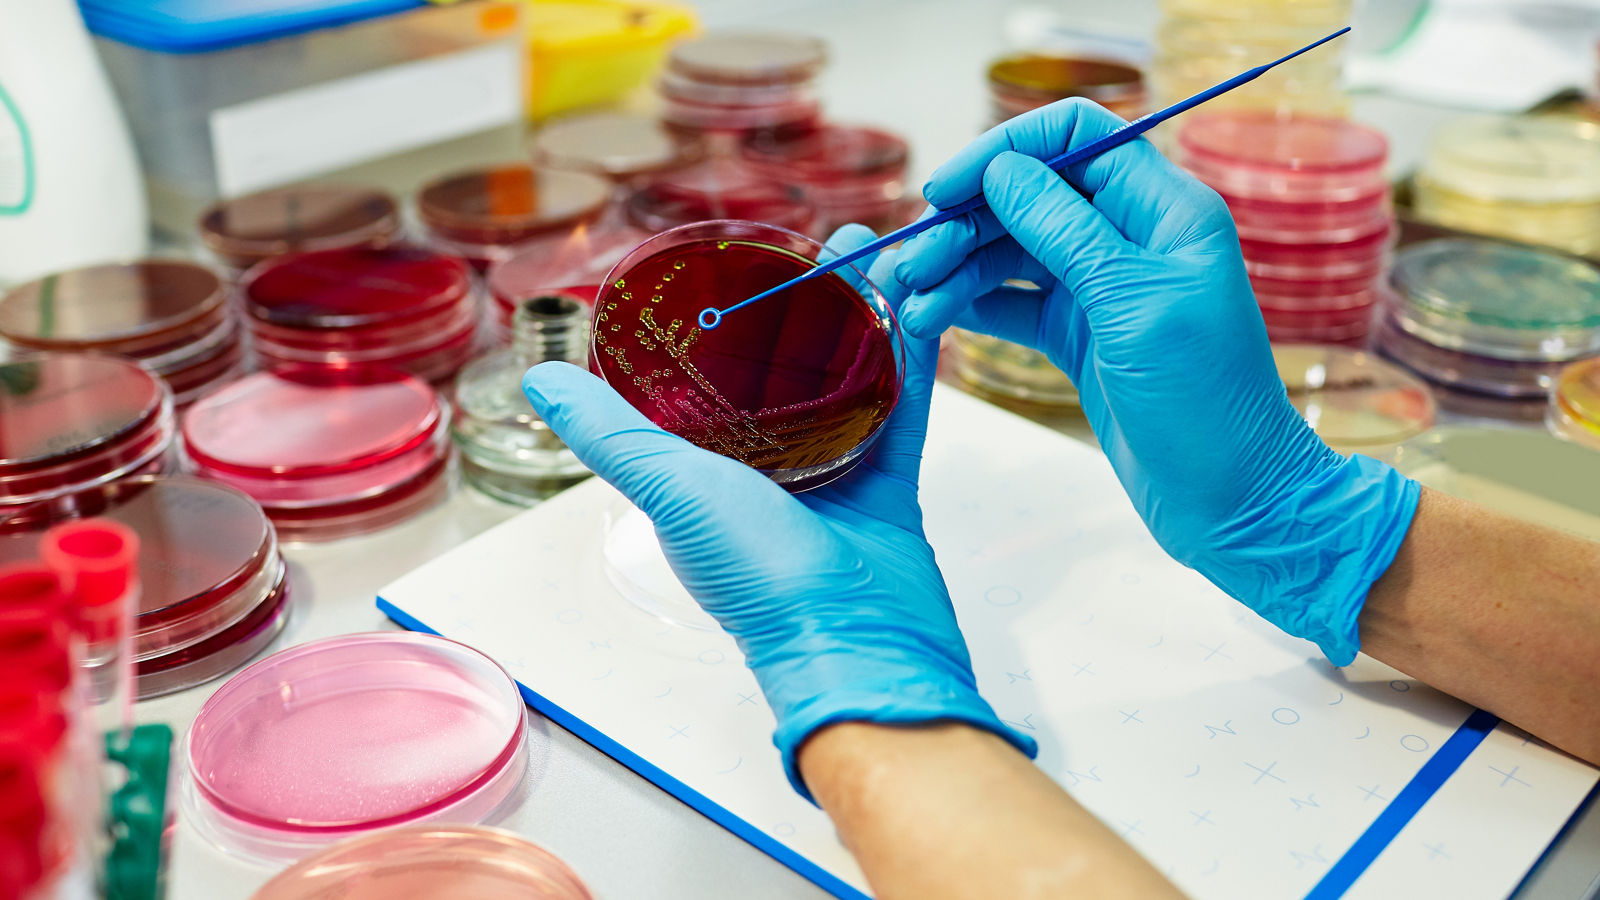
petri dish with red reagents in arm of medical chemist wearing protactive disposable gloves

Die ersten Anzeichen treten nach seiner Rückkehr aus dem Griechenlandurlaub auf: Thomas Herrschen* fühlt sich schlapp und antriebslos. Eine Erkältung, denkt er. Doch die anfängliche Schwäche steigert sich, er bekommt immer wieder Atemnot. Schließlich geht es ihm so schlecht, dass er den Rettungsdienst ruft. In der Notaufnahme der Helios St. Anna Klinik stellen die Ärzte schnell fest, dass der 58-Jährige nicht nur Wasser in Lunge und Beinen einlagert, sondern auch die Weichteile seiner Bauchdecke entzündet sind. Die Folge: eine lebensbedrohliche Sepsis. Das Team startet die Behandlung, doch die Diagnose bleibt weiterhin ein Rätsel? Woher kommen die Symptome? Trotz wiederholter Proben und Antibiotikatherapie finden sie den auslösenden Erreger nicht. Thomas Herrschens Organe versagen langsam, insbesondere Leber und Nieren. Um seine Überlebenschancen zu erhöhen, versetzen die Ärzt:innen ihn in ein künstliches Koma.
Dieser Fall weckt auch bei Dr. Benjamin Berlemann, Chefarzt der Kinderklinik in der Helios St. Johannes Klinik, Erinnerungen. Besonders einer ist ihm im Gedächtnis geblieben: In der Kindernotfallambulanz der Helios St. Johannes Klinik wurde damals ein dreijähriger Junge eingeliefert. Er litt unter starken Bauchschmerzen mit hohem Fieber. Schließlich verfärbten sich seine Augen hellgelb und der Urin dunkelbraun. Doch das Team konnte zunächst nichts finden: „Wir hatten alle möglichen Tests gemacht, die aber ergebnislos verliefen. Auch das Blutbild zeigte keine auffälligen Veränderungen. Dem Jungen aber ging es von Stunde zu Stunde schlechter“, erinnert sich der Pädiater. Ihm fällt schließlich ein Fachartikel ein, den er vor kurzem gelesen hatte und auf dessen Grundlage stellte er schließlich die richtigen Fragen. Denn die Familie war kurz zuvor in einem Streichelzoo gewesen, einschließlich längerem Besuch im Ziegengehege. Schnell ordnete das Team die entsprechenden Labortests an und behielt Recht: Der Dreijährige hatte sich mit dem sogenannten Q(uery)-Fieber angesteckt. Dessen Erreger – das Bakterium Coxiella burnetii – kann aus den Überresten von Nachgeburten oder zu Staub zerfallenem Kot von Ziegen oder Schafen über die Atemwege auf den Menschen überspringen und sich unerkannt zu schwerer chronischer Müdigkeit oder sogar einer Entzündung der Herzinnenhaut (Endokarditis) entwickeln. Auch Zecken oder nicht durchgegartes Fleisch können die Ursache sein, in Deutschland schwankt die Anzahl der Betroffenen im Jahr zwischen 50 und 400 (2023 waren es laut RKI beispielsweise rund 70 gemeldete Fälle). Für die Tiere selbst ist das harmlos, aber bei Kindern oder immungeschwächten Menschen droht im schlimmsten Fall Lebensgefahr. Und manchmal sogar bei gesunden Menschen. Wie bei Thomas Herrschen. Denn schließlich fanden auch die Ärzt:innen im St. Anna heraus, dass er sich offenbar in Griechenland mit dem Q-Fieber angesteckt hatte. Sofort passten sie die Medikation an und retteten so sein Leben. Auch Dr. Berlemanns kleiner Patient schaffte es damals.
Diese sogenannten Zoonosen – also Erkrankungen, die von Tieren auf Menschen übertragen werden – sind zum Glück sehr selten, machen es den Mediziner:innen aber oftmals besonders schwer. Viele kündigen sich mit unspezifischen Symptomen an und zeigen bei den üblichen Untersuchungen, etwa im Blutbild, kaum Spuren. Um die auslösenden Bakterien oder Viren zu enttarnen, müssen die Ärzt:innen sich auf eine kniffelige Spurensuche im Umfeld der Patient:innen begeben. Gibt es Haustiere? Auslandsaufenthalte? Die Liste der möglichen Krankheiten ist lang – insgesamt sind es rund 200 beschriebene – und manchmal braucht es Jahre, bis sie entdeckt werden. Die sogenannte „Rinder-Malaria“ zum Beispiel wird von Zecken übertragen und verursacht langanhaltende Beschwerden, ähnlich jenen in den Wechseljahren. Mit Glück lassen sich die Erkrankungen – einmal entdeckt – auch gut behandeln, so wie das Q-Fieber. Doch bei anderen leiden die Betroffenen manchmal ein Leben lang unter den Nachwirkungen. Wie bei der alveolären Echinokokkose, einer seltenen, aber schwerwiegenden parasitären Erkrankung, die durch den Fuchsbandwurm Echinococcus multilocularis verursacht wird (in Deutschland gibt es jährlich nur rund 20 bis 30 dieser Fälle). Menschen können sich durch den Kontakt mit kontaminiertem Boden, Wasser oder Lebensmitteln anstecken. Die Larven des Parasiten schädigen langfristig die Leber – dort bilden sie verkapselte Zysten – können aber auch auf andere Organe wie die Lunge oder das Gehirn übergehen. Die Therapie ist oft umfassend, Teile der Leber müssen entfernt werden, dazu eine medikamentöse Therapie. Einige der Betroffenen leiden trotzdem langanhaltend unter Funktionsstörungen des Organs oder Rezidiven.
Ob Zoonosen generell zunehmen, ist nicht eindeutig geklärt, aber bestimmte Entwicklungen wie Veränderungen des Klimas, globalisiertes Reisen oder zunehmende Urbanisierung bestimmter Gegenden begünstigen den Kontakt von Menschen mit bestimmten Erregern. Für Ärzt:innen hierzulande Anlass genug, diese Erkrankungen bei einer kniffligen Suche nach der richtigen Diagnose immer miteinzubeziehen.








